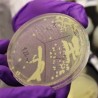
Синтетички хромозом - корак ка вештачком животу

Здравље
понедељак, 07. апр 2014, 14:45 -> 16:55
Кључ је у седам порција воћа и поврћа!
Само две порције више од препоручених пет могу да направе такву разлику у здравственом стању појединца да се ризик од преране смрти смањује 42 одсто...
понедељак, 07. апр 2014, 13:00 -> 13:58
Аеробик користан за функцију мозга
Налази научника Универзитета „Минесота“ показали су да бављење аеробиком у двадесетим има позитиван утицај на функције мозга у средњим годинама...
уторак, 01. апр 2014, 14:00 -> 14:50
Намирнице које успоравају старење
Риба, маслиново уље, чоколада и јогурт налазе се на листи намирница које чуда чине за здравље, а самим тим и за лепоту и младост тела. Не заборавите ни боровнице и орашасте плодове, а понекад уживајте...
уторак, 01. апр 2014, 13:02 -> 13:40
Кухињски калфа: „Салата са морским плодовима“
Сваког уторка проверавамо како кувају ученици угоститељских школа у Србији. Камере РТС-а снимиле су у школским кухињама и ресторанима рецепте за здраве, јефтине и лепе оброке. На реду је „Салата са морским...
понедељак, 31. мар 2014, 12:32 -> 13:09
Срце воли брак
Жене и мушкарци који су у браку мање пате од срчаних обољења и болести крвотока у односу на самце, разведене и оне чији су брачни другови умрли, показало је истраживање америчких стручњака...
недеља, 30. мар 2014, 18:38 -> 19:42
Крпељи – мали убод, велика опасност
Одећом заштитите кожу од крпеља, а по повратку из природе добро проверите да неки, ипак, није доспео где не треба. У случају да јесте, најбоље је обратити се лекару, јер постоји могућност да је инсект...
субота, 29. мар 2014, 14:31 -> 15:42
Срце на удару након померања сата
Понедељком након пролећног померања часовника учесталост срчаних удара расте 25 одсто, указују амерички стручњаци подсећајући још једном на осетљивост тела на другачије рачунање времена...
субота, 29. мар 2014, 00:42 -> 01:07
Мушки проблеми о којима се ћути
Еректилна дисфункција или једноставније речено сексуална немоћ, успешно се лечи само код лекара. Зато је препорука да мушкарци имају свог уролога, као што жене имају гинеколога. Ипак, мушкарци најчешће...
петак, 28. мар 2014, 10:08 -> 16:34
Синтетички хромозом - корак ка вештачком животу
Тим научника је успео да произведе синтетички хромозом пивског квасца, што је још један корак ка стварању вештачког живота. Убудуће ће бити могуће развијање вештачке врсте квасца способне да произведе...
четвртак, 27. мар 2014, 12:29 -> 13:19
Бресквама против рака дојке
Спасоносан савезник у борби против рака дојке може да буде мала, сласна бресква! Само три ароматична плода дневно могу да направе значајну разлику, тврде амерички научници...

Коментари